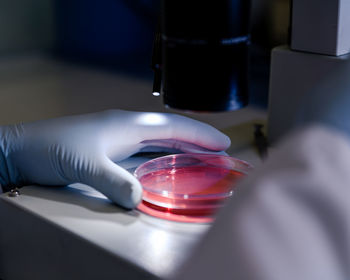
Cropped hand of scientist holding petri dish on table

Bioscience

Portrait of female friends standing in laboratory

Biomass energy research conducted in laboratory

Close-up of bottles

Cropped hands of scientist holding microscope slide

Midsection of man working in laboratory

Rear view of man working in laboratory

Technician conducts biomass energy research conducted in laboratory

Bioscience research in a laboratory

Bioscience research in a laboratory

Biomass energy research conducted in laboratory

Bioscience research in a laboratory

Bioscience research in a laboratory

Rear view of man wearing protective mask

Cropped hands of scientist holding petri dish on microscope

Close-up of young man drinking water

Biomass energy research conducted in laboratory

Close-up of computer on table

Portrait of young woman standing in city

Rear view of architects working at construction site

Culture in a petri dish under stereomicroscope is examined for pharmaceutical bioscience research.

Biomass energy research conducted in laboratory

Biomass energy research conducted in laboratory

Biomass energy research conducted in laboratory

Rear view of woman using mobile phone

Bioscience research in a laboratory

Technician conducts biomass energy research conducted in laboratory

Portrait of senior man wearing hat

Biomass energy research conducted in laboratory

Portrait of young man using mobile phone
Cropped hand of scientist holding petri dish on table

Rear view of man working in laboratory

Portrait of young man smoking cigarette

Midsection of doctor holding dentures

Portrait of female friends standing in clinic

Various plant stocks grown for biomass research

Side view of woman using mobile phone

Side view of young woman drinking glass

Portrait of man standing in office

Bioscience research in a laboratory

Young female doctor using mobile phone in laboratory

Biomass energy research conducted in laboratory

Portrait of young man using mobile phone in office

Portrait of young woman standing in laboratory

Bioscience research in a laboratory

Bioscience research in a laboratory

Biomass energy research conducted in laboratory

Rear view of man using digital tablet while sitting at office

Female doctor examining patient in laboratory

Side view of female friends standing in factory

Bioscience research in a laboratory

Side view of young woman standing against building

Bioscience research in a laboratory

Biomass energy research conducted in laboratory

Interior of laboratory

Side view of man working in laboratory

Close-up of computer on table

Young man working at laboratory

Scientist examining patient in laboratory

Rear view of woman standing in laboratory

Rear view of man working in office

Side view of doctor examining patient in hospital

Rear view of female friends standing in factory

Side view of man working in office

Bioscience research in a laboratory

Rear view of man working in laboratory

Portrait of young woman using mobile phone

Rear view of man using mobile phone

Rear view of man wearing hat

Doctor examining chemical in laboratory

Rear view of female friends standing in hospital

Rear view of woman standing in factory

Portrait of young man using digital tablet

Bioscience research in a laboratory

Cropped image of scientist by microscope in laboratory

Female doctor examining chemical in laboratory